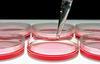

Най-мащабната европейска колекция за клетъчни култури (ECACC) 30 август 2007

Клетъчните култури и техни продукти все повече се използват в биотехнологиите и са съществени за изследвания като throughput скрининга, токсикологията и други биологични експерименти. За да бъдат подготвени и да се гарантира тяхната достоверост, всички реагенти и базични продукти са стандартизирани и с определено качество по отношение на която и да е клетъчна линия.

Доставката на клетъчни линии може да бъде печелившо звено, което трудно се поддържа. Често компаниите прибягват към странични ресурси от изследователските програми или инвестират в скъпоструващи роботизирани системи за задоволяване техните нужди от клетки.
 ECACC предлага алтернатива.
ECACC предлага алтернатива.Тук сме, за да подпомогнем компаниите да поддържат клетъчните култури в техните лаборатории като предлагаме обучение и предоставяме на клиентите помощни партньори. Можем да осигурим клетки, които да поддържат цели програми от нашите колекции или от от клетъчни линии предоставени от клиента.
Услугите, които предоставя ECACC, включват:• Навременни или допълнителни обучаващи курсове, които могат да се адаптират съобразно нуждите на клиента.
• Характеризиране на клетките, което включва определяне на типа и анализиране на клетъчния растеж
• Поддържане на клетъчна банка със сигурно качество от над 200 ампули
• Клетки готови за експерименти
• Генно модифициране на клетки с вектори по желание на клиента
• Адаптиране и съхранение без серум
• Качествен контрол
Повече за ECACC
Повече за ECACCС частично седалище във Великобритания, Европейска колекция за клетъчни култури (ECACC), е най-голямата организация за съхранение, поддържане и работа с клетъчни култури.
Тя е част от групата клетъчни колекции, принадлежаща на Агенцията за защита на здравето (HPA).
www.doctorbg.com